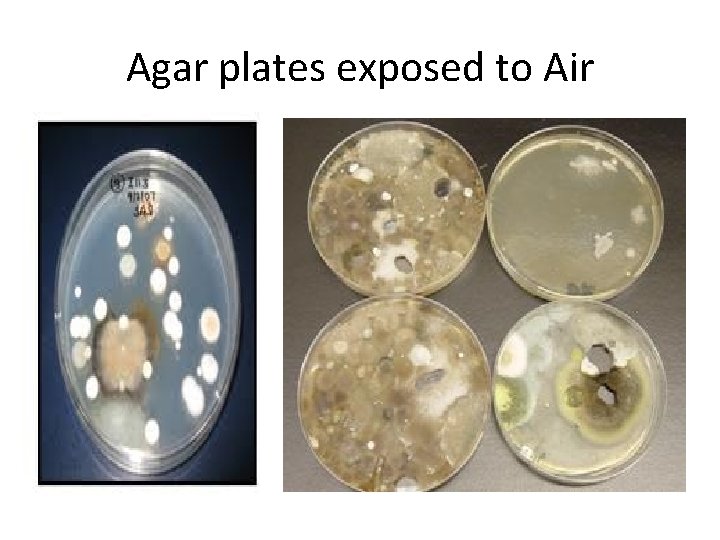
Agar plates exposed to Air
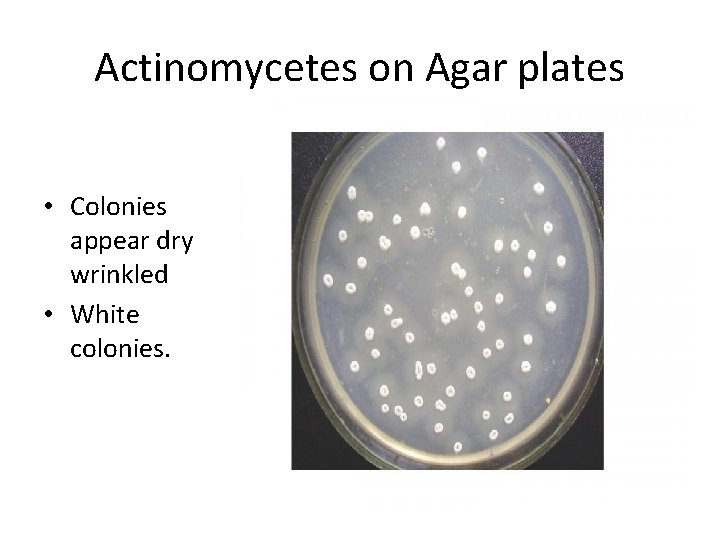
Actinomycetes on Agar plates • Colonies appear dry wrinkled • White colonies.

Practical 12 Environmental Sampling Microbiological Sampling of Air

Practical 1&2 Environmental Sampling Microbiological Sampling of Air

Environmental Sampling • Environmental microbiology is not clinical microbiology(Air, water , soil, food , etc. ) • Random, undirected sampling is not recommended • Sampling requires a protocol for sampling and culturing, analysis of results, and action based on the interpretation of results

General Environmental Sampling • Suggested uses: – Outbreak investigation – Research in Environmental infection control – Monitor a potentially hazardous situation – Evaluate a change in environmental infection control for quality purposes – Periodic maintenance of equipment HAC systems ( heating &air conditioning system) – Legal issues

Environmental Sampling Problems • Expensive • Time-consuming • Subject to many variables in protocol, analysis, and interpretation • Why difficult and problematic – No baselines, no acceptable ranges – Few protocols for conducting planned, directed environmental studies in health care settings. – The investigator is required to minimize false negatives and false positives.

Air Sampling Why do Air Sampling? • Verification of ventilation and cleanliness – Establish baseline data • Post infection evaluation (outbreak investigation) – Rule out ventilation as a source – Discover source of infectious fungi (reservoir) • Construction, renovation, repair of certain buildings such as hospitals • Employee complaints

Microorganisms of the air Important Facts: • Air has no indigenous or native flora • Organisms are found temporarily suspended in air or carried on dust particles or droplets • Air is not sterile • Air does not support the growth of organisms

Before Microbiological Air Sampling… • Define your objective and analytical approach – Qualitative vs. quantitative • Compare indoor results to counts from outdoor air • Fully describe the circumstances in the area where sampling is occurring • High volume sampling most efficient

Poor Ventilation • Inadequate ventilation can increase indoor pollutant levels by not bringing in enough outdoor air to dilute emissions from indoor sources and by not carrying indoor air pollutants out of the home. • High temperature and humidity levels can also increase concentrations of some pollutants.

Air Sampling • To determine bacteria and fungi identities and concentration in biological aerosols • Major methods: – Impingement in liquids – Impaction on solid surfaces – Sedimentation (e. g. , settle plates) • Requires an understanding of what is being measured and a full description of the circumstances during sampling

Compare and Contrast the Main Air Sampling Methods Method Principle Suitable for Measuring Impingement in liquids Air drawn in through small jet, directed against liquid surface Viable microorganisms, water aerosols Impaction on solid surface Air drawn into sampler, particles deposited on dry surface(slide, Agar) Sedimentation (settle plates) Particles and microorganisms settle via gravity Collection Media or Surface Points to Consider Buffered gelatin, peptone, nutrient broth, tryptose saline Used for Legionella spp. sampling Dry surfaces, coated surfaces, agar Used for bacteria and fungal agent sampling; high volumes can be sampled Nutrient agars in plates Simple, best suited for qualitative sampling; not used for fungal spores Viable particles, viable microorganisms

Types of Air Samplers* A. B. C. A. Impactor sampler B. Glass impinger sampler C. Sieve impactor sampler

How to Sample for Viable Mold and Bacteria • Non-viable spore – Air sampling cassette (slide) (Auto or trap–sampler) • Viable Sampling – Active ( membrane /media) • Surface Air Sampler (SAS) – Passive • Settle Plates SAS

Air sampling cassette It is designed for the rapid collection of a wide range of airborne aerosols including mold spores, pollen, insect parts. It collects both viable and non-viable sample specimens. After sampling is completed, the cassettes are sent to a laboratory, where the slides are removed and direct microscopic analysis can be immediately performed.

Practical work • Each 2 students will have 2 PCA plates, and should perform gravity method. • Expose one plate indoor , and one outdoor for 1 hour. ( Care taken to choose different areas) • Properly label your plates ( indoor or outdoor , name of place, time, duration, student name) • Bring to lab next day. Incubate at 37 c for 48 hours, then read results with instructor.

Results • It is important to compare No and type of organisms grown on plates between indoor and outdoor. • A lot of bacteria such as colored Micrococci, Actinomycetes, Bacillus , Pseudomonas , etc. • A lot of fungi , molds and yeast. • Usually No of outdoor orgs is higher than indoor No. • If a predominant organism exist , this is not normal especially for indoor places. • High indoor No's are not normal in certain rooms.

General Control of Air Borne Diseases • Good ventilation( dilutes organisms) • Avoid overcrowding especially in closed places • Isolation of patients with serious respiratory infections • Wearing masks • Spacing of beds or desks • Disinfect air ( HEPA Filters, UV hoods) • Vaccination

HEPA Filter • High-efficiency particulate air filter • It removes 99. 97% of all particles greater than 0. 3 micrometer from the air that passes through • HEPA filters are critical in the prevention of the spread of airborne bacterial and viral organisms and infection • Medical-use HEPA filtration systems incorporate high-energy ultra-violet light units to kill off the live bacteria and viruses trapped by the filter media.

HEPA Filter • It is composed of a mat of randomly arranged fibers. The fibers are typically composed of fiberglass. • These particles are trapped through a combination of the following three mechanisms: interception, impaction, diffusion.

HEPA Like Air Filters MERV(1 -20) MERV: Minimum Efficiency Reporting Value rating These ratings are used to rate the ability of an air cleaner filter to remove dust from the air as it passes through the filter. MERV is a standard used to measure the overall efficiency of a filter. The MERV scale ranges from 1 to 20, and measures a filter's ability to remove particles from 10 to 0. 3 micrometer in size 7 8 11 14
Agar plates exposed to Air
Actinomycetes on Agar plates • Colonies appear dry wrinkled • White colonies.

Actinomycetes gram stained smear Gram +ve branching rods

Yeast stained smear

Unresolved Issues and Microbiologic Air Sampling Unknown incubation period Infectious dose for Aspergillus spp. is unknown Lack of standard sampling protocols No standards or action levels for results Variability and sensitivity of sampling devices Lack of details : re sampling makes comparison of results with other outbreaks difficult • Lack of correlation between fungal strains in clinical specimens and those found in the environment • • •


Common biological contaminants • Include mold, dust mites, pet dander (skin flakes), droppings and body parts from cockroaches, rodents and other pests or insects, viruses, and bacteria. • Many of these biological contaminants are small enough to be inhaled. Biological contaminants are, or are produced by, living things. • Biological contaminants are often found in areas that provide food and moisture or water. For example, damp or wet areas such as cooling coils, humidifiers, condensate pans, or unvented bathrooms can be moldy. Draperies, bedding, carpet, and other areas where dust collects may accumulate biological contaminants
- Slides: 26